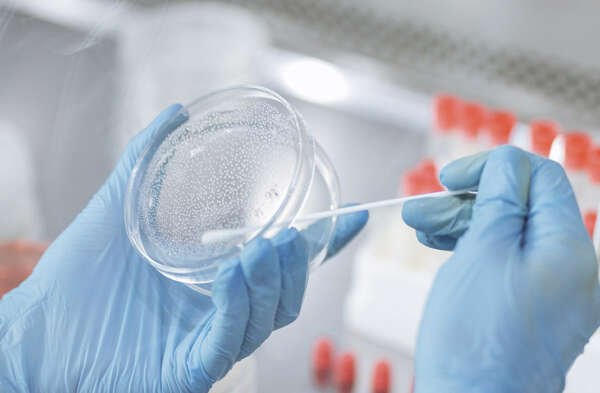
InmunoVet_MICROBIOLOGIA

ANÁLISIS VET

Beneficios que brindamos
El más amplio menú de pruebas
Realizado por tecnólogos médicos
Control de calidad integrado en nuestros análisis
Servicio gratuito de recolección de muestras
Asesoramiento clínico por médicos veterinarios
Analizadores de alta tecnología en veterinaria
Resultados rápidos en línea y WhatsApp
Análisis con el mejor precio del mercado
Compromiso con la Calidad
Proporcionamos a nuestros médicos veterinarios resultados de calidad, asegurándonos con controles internos en hematología, bioquímica e inmunología, además de políticas de calidad para la mejora continua y así estandarizar los procesos con el fin de garantizar resultados confiables.